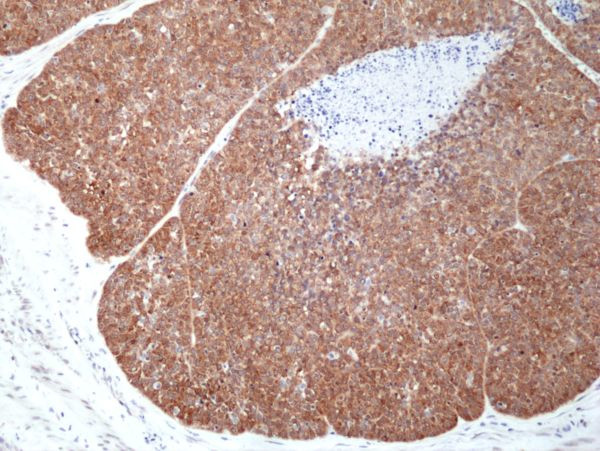
MSI2 Antibody in Immunohistochemistry (Paraffin) (IHC (P))

Search
Invitrogen
MSI2 Recombinant Rabbit Monoclonal Antibody (RM422)
{{$productOrderCtrl.translations['antibody.pdp.commerceCard.promotion.promotions']}}
{{$productOrderCtrl.translations['antibody.pdp.commerceCard.promotion.viewpromo']}}
{{$productOrderCtrl.translations['antibody.pdp.commerceCard.promotion.promocode']}}: {{promo.promoCode}} {{promo.promoTitle}} {{promo.promoDescription}}. {{$productOrderCtrl.translations['antibody.pdp.commerceCard.promotion.learnmore']}}
产品信息
MA5-36217
种属反应
宿主/亚型
Expression System
分类
类型
克隆号
抗原
偶联物
形式
浓度
规格
纯化类型
保存液
内含物
保存条件
运输条件
RRID
产品详细信息
MA5-36217 reacts to human Musashi 2. This antibody may also react to mouse or rat Musashi 2, as predicted by immunogen homology.
靶标信息
Msi2 (musashi homolog 2), also known as MSI2H, is a 328 amino acid protein that localizes to the cytoplasm and contains two RRM (RNA recognition motif) domains. Expressed ubiquitously at low levels, Msi2 functions as an RNA binding protein that, by regulating the expression of target mRNAs, is thought to play a role in the proliferation and maintenance of stem cells within the central nervous system. Msi2 is subject to posttranslational phosphorylation and is upregulated in response to brain injury, suggesting a role in healing and brain tissue regeneration. Chromosomal aberrations involving the Msi2 gene are associated with the progression of chronic myeloid leukemia. Multiple isoforms of Msi2 exist due to alternative splicing events.Tissue specificity: Ubiquitous; detected at low levels.
仅用于科研。不用于诊断过程。未经明确授权不得转售。
篇参考文献 (0)
生物信息学
蛋白别名: musashi homolog 2; Musashi-2; RNA-binding protein Musashi homolog 2; unnamed protein product
基因别名: MSI2; MSI2H
UniProt ID: (Human) Q96DH6
Entrez Gene ID: (Human) 124540